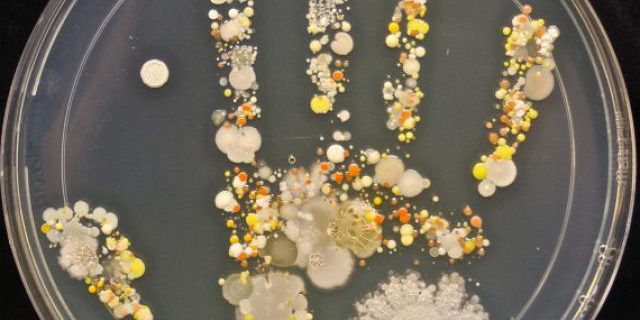
germes germes

-
Oublier de se laver les mains avant de les manipuler (pose ou retrait !)

Une bonne hygiène est indispensable au port de lentilles de contact en toute sécurité. Même si nos mains ont été lavées quelques minutes avant de manipuler les lentilles, elles ont pu entre-temps rencontrer différents objets qui peuvent s’avérer être de véritables « nids à microbes » (poignées de porte, télécommandes, jouets, éponge, chien ou chat …).
Sans un lavage minutieux précédent de manière imminente la manipulation des lentilles, toute cette flore microbienne risque de se retrouver en contact avec les lentilles puis dans les yeux !
De plus, les lentilles souples agissant telles des éponges (elles absorbent les larmes et tout ce qu’elles contiennent), les microbes auront le loisir de se développer en toute tranquillité dans un bain constitué par les larmes, à 35-37°.
Les complications peuvent être de banales (ex. conjonctivite : inflammation de la conjonctive) à plus compliquées et douloureuses (ex. kératite : inflammation de la cornée) voire définitives (ex kératite bactérienne : réduction définitive de la vision).
Conclusion : lavez-vous les mains juste avant de mettre et de retirer vos lentilles !
- Ne pas changer le produit d’entretien après chaque retrait des lentilles

Le « topping off » est une habitude particulièrement dangereuse de certains utilisateurs qui veulent faire des économies sur leurs solutions d’entretien et préfère ainsi redéposer leurs lentilles dans la solution de la veille en complétant avec quelques gouttes de solution fraiche seulement et ainsi « refaire le niveau ».
Les rôles des solutions multifonctions ou « tout-en-un », qui est le mode d’entretien le plus utilisé, sont de nettoyer, décontaminer, hydrater, lubrifier les lentilles de contact. Par conséquent, le matin, après trempage des lentilles, le liquide résiduel se trouve constitué de multiples dépôts (maquillage, graisse, etc) mais surtout de microbes (bactéries, champignons, etc).
Ne pas jeter et renouveler cette solution reviendraient à se baigner tous les soirs dans le même bain que la veille !
Seule exception acceptable : si les lentilles ne sont pas portées plusieurs jours de suite, il faudra néanmoins veiller à changer le produit toutes les semaines environ et refaire un cycle de nettoyage complet la veille du jour où les lentilles seront remises.
Remarque importante : à la pose, une fois l’étui vidé de son contenu, il faudra prendre soin de ne pas le refermer immédiatement mais au contraire le laisser sécher à l’air libre afin d’éviter tout champignon qui pourrait être amenée à se développer dans l’humidité résiduelle.
Conclusion : après chaque pose, bien vider TOTALEMENT son étui et à après chaque retrait, bien masser les lentilles et remplir l’étui jusqu’au trait.
- Porter ses lentilles de 7h du matin à 23h
Le port de lentilles souples ne doit pas excéder une douzaine d’heures par jour (excepté pour les lentilles en port continu, c’est-à-dire qui se gardent la nuit, mais qui restent des cas exceptionnels, prescrits par le médecin).
En effet, même si les matériaux ont fortement évolué ces dernières années, la grande majorité d’entre eux ne permet pas un port prolongé dans des conditions de sécurité convenables et risque donc d’occasionner un manque d’oxygène qui peut s’avérer néfaste à la cornée, hublot transparent sur lequel est placée la lentille. La cornée n’étant pas vascularisée, son unique système de défense est représenté par la barrière épithéliale constituée par les couches de cellules à sa surface : il est donc impératif pour sa survie, qu’elle ne soit jamais blessée.
Conclusion : il est vivement conseillé de limiter le temps de port à une douzaine d’heures par jour et 6 jours par semaine.
- Garder ses lentilles à la piscine

Des parasites de type protozoaire, les amibes, sont présents dans toutes les eaux douces non parfaitement stériles, en particulier l’eau du robinet, les eaux minérales, l’eau de piscine, etc.
Ils se caractérisent par leur existence sous deux états :
– en milieu hostile, l’amibe entre en état de kyste, ne se nourrit pas, ne bouge pas et peut se retrouver dans l’eau du robinet. Elle résiste bien au chlore et aux désinfectants habituels.
– en milieu favorable – entre 20 et 30 °C – et nourricier, le kyste redonne naissance à une nouvelle génération d’amibes capables de se déplacer et de se nourrir.
Après un passage à la piscine, le kyste amibien se retrouve à nouveau dans un milieu favorable, en l’occurrence, les tissus cornéens. Les porteurs de lentilles de contact sont alors un groupe à haut risque de contamination car la cornée, dépourvue de circulation sanguine, ne peut donc pas compter sur le système immunitaire classique du corps humain pour se défendre.
Conclusion : Il est donc particulièrement important de ne pas garder ses lentilles de contact à la piscine, sans un masque ou une paire de lunettes de plongée, ou alors, de les jeter tout-de-suite après. Les lentilles journalières sont alors idéales pour cet usage.
- Conserver ses lentilles au-delà de leur durée de vie (ex : plusieurs jours pour une journalière ou plus d’un mois pour une mensuelle)
Toutes les lentilles de contact ont une durée de vie déterminée par le fabricant. Celle-ci est extrêmement variable d’une lentille à l’autre puisqu’elle peut aller d’une journée (pour les journalières) à plusieurs mois (pour les traditionnelles). Elle correspond à la durée pour laquelle la lentille est assurée de conserver toutes ses caractéristiques d’origine : perméabilité à l’oxygène, résistance, qualité de surface, résistance aux dépôts, etc. Passé ce délai, en général, la qualité de la lentille diminue sensiblement (vision, confort) et peut, si le port se prolonge, altérer la bonne santé oculaire.
Conclusion : il est important de bien respecter la durée d’utilisation recommandée des lentilles souples afin de limiter les risques de mésusage.
D’une manière générale, un œil qui pique, qui gratte, qui fait mal
lors du port des lentilles n’est jamais à prendre à la légère.
Il convient de les retirer immédiatement et de surveiller l’évolution des symptômes
pendant quelques heures après leur apparition.
S’ils ont tendance à persister, voire à augmenter,
il faut alors contacter rapidement un ophtalmologiste.
Aventure malheureuse d’une étudiante : l’accumulation des risques peut devenir catastrophique.
Le cas d’accident le plus grave par mésusage des lentilles recensé est celui de Lian Kao, une étudiante taïwanaise de 23 ans qui a perdu la vue. Alors que la jeune femme aurait dû jeter ses lentilles mensuelles après un mois d’utilisation en prenant soin de ne pas les porter plus d’une douzaine d’heures par jour, elle les a gardées pendant six mois, de façon ininterrompue, en toutes occasions que ce soit sous la douche ou à la piscine. Cette “négligence” a déclenché chez elle une kératite amibienne, inflammation de la cornée due au développement d’amibes, entre la lentille et la surface de son oeil. La surface des yeux de la jeune fille a été littéralement « rongée » par l’amibe, occasionnant une cécité irréversible.